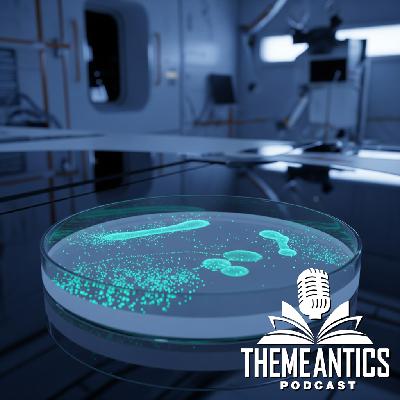

Discover
ThemeAntics Podcast
ThemeAntics Podcast
Author: Bradston Henry and Devonte’ Godfrey
Subscribed: 0Played: 4Subscribe
Share
© Copyright 2024 All rights reserved.
Description
We’re fiction enthusiasts and aspiring writers. We’re doing a podcast about themes in fiction and how we can story differently with them.
Each podcast, we dive into a popular theme in fiction and take a look at interesting examples of how these themes are used in media.
To wrap up each episode, we work to improvise creative and alternative ways to story differently with these themes.
Hosted by Devonte’ Godfrey and Bradston Henry.
Each podcast, we dive into a popular theme in fiction and take a look at interesting examples of how these themes are used in media.
To wrap up each episode, we work to improvise creative and alternative ways to story differently with these themes.
Hosted by Devonte’ Godfrey and Bradston Henry.
35 Episodes
Reverse
In this episode, Bradston and Devonte’ discuss the well-known and controversial (?) novel "The Da Vinci Code" by Dan Brown. The novel also inspired a film adaptation starring Tom Hanks.
Put on your escape room detective cap as the guys navigate this puzzle of an adventure while unpacking notable themes they noticed. They also examine the real-world implications of a story that invokes a plethora of alternate history and conspiracy theories. Lastly, the guys share their thoughts on whether or not the ultimate reveal is a satisfying conclusion to the novel's intricate story.
Website: https://themeanticspodcast.podbean.com/
Email: ThemeAnticsPod@gmail.com
Blog: https://medium.com/@themeanticspodcast
Linktree: https://linktr.ee/ThemeAnticsPodcast
The Bible is a collection of 66 books with a wide variety of writing styles, themes, and narratives. It is undoubtedly one of the most influential pieces of literature in human history. It's not surprising that so many works of art (fiction and nonfiction) have been based, or loosely based, on its stories.
Bradston and Devonte’ discuss a few examples of how stories have used biblical narrative in distinct ways. Afterwards, the guys workshop creative ideas for telling different types of stories that center characters and themes from scripture in a way that is accessible to anyone, regardless of religion.
Website: https://themeanticspodcast.podbean.com/
Email: ThemeAnticsPod@gmail.com
Blog: https://medium.com/@themeanticspodcast
Linktree: https://linktr.ee/ThemeAnticsPodcast
Welcome to another FANtastic episode of ThemeAntics (we had to do it)! Bradston and Devonte’ jump back into the superhero genre as they highlight key themes and moments from the recent theatrical release of Fantastic Four: The First Steps.
The guys also discuss what worked about the movie and its style of storytelling. With comic book characters and multiversal shenanigans galore, the Antics was again full of exciting alternate story possibilities!
Website: https://themeanticspodcast.podbean.com/
Email: ThemeAnticsPod@gmail.com
Blog: https://medium.com/@themeanticspodcast
Linktree: https://linktr.ee/ThemeAnticsPodcast
Have Ryan Coogler and Michael B. Jordan cemented their status as this era’s paramount director + leading actor duo? Bradston and Devonte’ believe so!
The guys recently watched another one of 2025’s most impactful movies and unpack the multitude of themes and highlights within the unique story. In a story dense with both lore and new ideas, Antics was loaded with plenty of alternate story potential as always!
Website: https://themeanticspodcast.podbean.com/
Email: ThemeAnticsPod@gmail.com
Blog: https://medium.com/@themeanticspodcast
Linktree: https://linktr.ee/ThemeAnticsPodcast
K-Pop! Demon Hunters! Music! Couch! Masterpiece!
Bradston and Devonte’ were recently blown away by the vibrant, electric film, “K-Pop Demon Hunters”; A movie about a trio of K-Pop stars who battle demons (literally and figuratively) as chosen Hunters.
The ThemeAntics band breaks down the movie's references to Korean folklore, the power of music in storytelling, and their favorite themes used throughout the story. With the movie's creative world-building and character development, there was an abundance of prequel/sequel/spinoff antics for the guys to uncover!
WARNING: The soundtrack for "K-Pop Demon Hunters" is irresistible and extremely catchy. Side effects include random musical ad libs and attempted singing, both of which are present in this episode. HUNTRIX DON'T MISS!
Website: https://themeanticspodcast.podbean.com/
Email: ThemeAnticsPod@gmail.com
Blog: https://medium.com/@themeanticspodcast
Linktree: https://linktr.ee/ThemeAnticsPodcast
Sometimes, truth is stranger than fiction. Time will tell if that is the case for recent scientific news of a mysterious bacterium discovered on the Chinese space station, Tiangong.
In this episode, Bradston and Devonte’ give their thoughts on the news and what sci-fi themes it reminds them of. The ‘Antics’ discussion is one you don’t want to miss as the guys craft a sprawling, increasingly dense spin on this story that re-imagines the nature of extraterrestrial life… and how humans could engage it.
Chinese Space Station Bacterium Article: https://farmingdale-observer.com/2025/05/26/an-unknown-bacteria-on-earth-has-developed-in-the-chinese-space-station-astronauts-are-facing-a-situation-straight-out-of-a-science-fiction-movie/
Website: https://themeanticspodcast.podbean.com/
Email: ThemeAnticsPod@gmail.com
Blog: https://medium.com/@themeanticspodcast
Linktree: https://linktr.ee/ThemeAnticsPodcast
Bradston and Devonte’ get around to discussing a show both have been eager to discuss: 3 Body Problem (Netflix version) based on the novel series by Liu Cixin. The guys navigate this sprawling story with plenty of intrigue and mystery and unpack how the show makes good use of multiple sci-fi themes we are all familiar with.
This is one of the most thought-provoking stories discussed on the podcast and the audience will have as much fun listening to it as the guys did talking about it!6
Website: https://themeanticspodcast.podbean.com/
Email: ThemeAnticsPod@gmail.com
Blog: https://medium.com/@themeanticspodcast
Linktree: https://linktr.ee/ThemeAnticsPodcast
Mystery is one of the oldest themes in storytelling. For ages, people have been drawn into tales of murder, theft, and countless other crimes. The hook to the story is almost always the same: Whodunit?
In this episode, Bradston and Devonte’ grab their magnifying glasses and notepad to solve the mystery of how these stories enrapture our curiosity and leave a lasting impact …. with bloody footprints.
Timestamps:
(00:00:00) - Welcome to ThemeAntics
(00:00:48) - Introducing the Theme
(00:03:50) - Knives Out
(00:12:30) - The Forgotten Room
(00:22:55) - The Seven Deaths of Evelyn Hardcastle
(00:31:50) - Resonance
(00:43:05) - Antics
Website: https://themeanticspodcast.podbean.com/
Email: ThemeAnticsPod@gmail.com
Blog: https://medium.com/@themeanticspodcast
Linktree: https://linktr.ee/ThemeAnticsPodcast
Waves the height of buildings, winds lighting boats and other vehicles, earthquakes that rip entire cities apart, waterspouts spitting out great white sharks (!). All the carnage we have seen in disaster movies can frighten us, make us in awe of nature’s raw power, and sometimes (uncomfortably) laugh.
Bradston and Devonte’ pack their storm chasing gear and venture into the world of fictional and real world disaster stories. Other than the destruction, what do these movies tell us about ourselves and our relationship with nature? What brings out our indomitable nature in the unyielding face of catastrophe? Hear their thoughts and fun ideas for new stories in this mind-blowing episode (pun intended)!
Website: https://themeanticspodcast.podbean.com/
Email: ThemeAnticsPod@gmail.com
Blog: https://medium.com/@themeanticspodcast
Linktree: https://linktr.ee/ThemeAnticsPodcast
In this episode, Devonte’ and Bradston take on a lesser known Robert De Niro/Martin Scorsese movie: The King of Comedy.
This classic invokes interesting questions about reality, fantasy, ambition, and delusion. The guys examine how the movie incorporates these themes and how they would do it differently!
Timestamps:
(00:00:00) - Welcome to ThemeAntics
(00:00:48) - Discussing the Story and Theme of ‘The King of Comedy’
(00:59:35) - Storying Differently with ‘The King of Comedy’
Website: https://themeanticspodcast.podbean.com/
Email: ThemeAnticsPod@gmail.com
Blog: https://medium.com/@themeanticspodcast
Linktree: https://linktr.ee/ThemeAnticsPodcast
Throw on your thinking caps and jump into a wild (and slightly confusing) ride with Devonte’ and Bradston as they recap the time travel adventure Predestination (2014)!
Watching this movie is highly recommended to fully appreciate the discussion. Devonte’ and Bradston also share ideas on how the movie could have told its mind-bending story differently.
Timestamps:
(00:00:00) - Welcome to ThemeAntics
(00:00:48) - Discussing the story of Predestination
(00:48:00) - Storying Differently with Predestination
Website: https://themeanticspodcast.podbean.com/
Email: ThemeAnticsPod@gmail.com
Blog: https://medium.com/@themeanticspodcast
Linktree: https://linktr.ee/ThemeAnticsPodcast
We all have movies we keep rewatching, books we enjoy picking back up, reliable TV shows we rewind, and other stories we can't get enough of!
Bradston and Devonte’ share some of their favorite fiction works they often return to. They also discuss why their interest in familiar stories persists over time.
Timestamps:
(00:00:00) - Welcome to ThemeAntics
(00:00:48) - Introducing the Theme
(00:05:40) - Burn Notice
(00:16:00) - The Office (US version)
(00:26:45) - Toy Story (1995)
(00:36:00) - Full Metal Alchemist: Brotherhood
(00:45:25) - Antics/ Diving Deeper into why we return to stories
Website: https://themeanticspodcast.podbean.com/
Email: ThemeAnticsPod@gmail.com
Blog: https://medium.com/@themeanticspodcast
Linktree: https://linktr.ee/ThemeAnticsPodcast
After planning a standard episode, Bradston and Devonte’ called an audible to tackle an interesting, recent topic: mysterious drones being spotted in New Jersey and across the US.
The odd occurrences, many of them captured on video, are ripe for storytelling. Bradston and Devonte’ explore possible explanations and craft their own stories for these tantalizing UAP (unidentified aerial phenomenon) events.
Timestamps:
(00:00:00) - Welcome to ThemeAntics
(00:00:48) - Introducing the New Jersey Drone Incident
(00:36:25) - Antics with the NJ Drone Incident
Website: https://themeanticspodcast.podbean.com/
Email: ThemeAnticsPod@gmail.com
Blog: https://medium.com/@themeanticspodcast
Linktree: https://linktr.ee/ThemeAnticsPodcast
For this special episode, Devonte’ and Bradston take the gloves off and call out specific flaws in storytelling each of them have observed in fiction. Movies, video games, books, TV shows, everything is on the table!
To commemorate their first 20 (!) episodes of podcasting, they reflect on how they’ve made it to this point and their vision for the next 20 episodes and beyond. Onward and upward!
To everyone who has listened and supported, a big THANK YOU! As always, we are eager to hear your feedback and ideas.
Timestamps:
(00:00:00) - Welcome to ThemeAntics
(00:00:48) - Introducing the Theme
(00:04:15) - Books written to be movie scripts
(00:15:20) - Why does every reveal have to be Aliens or Ancient Civilizations
(00:22:00) - Not everything has to be an expansive universe
(00:31:15) - Not everything has to be a trilogy
(00:38:50 - Stop taking advantage of our Nostalgia
(00:46:30) - Not every main character has to be an Orphan
(00:52:45) - The goofy pure-hearted Sidekick always gets killed
(01:01:50) - Reflecting on 20 Episodes
Website: https://themeanticspodcast.podbean.com/
Email: ThemeAnticsPod@gmail.com
Blog: https://medium.com/@themeanticspodcast
Linktree: https://linktr.ee/ThemeAnticsPodcast
After a long and eventful election season, Bradston and Devonte’ kick back and remember some good political stories that are both entertaining and thought-provoking.
Considering how unhinged real-world politics can be, the ideas the guys piece together in the Antics section may not be as far-fetched as they seem!
Editorial Note: The First Lady that Devonte’ mentioned secretly assumed presidential duties for a brief period of time is actually Edith Wilson, wife of President Woodrow Wilson (who fell ill after World War I). Check out this interesting historical anecdote here: https://www.pbs.org/newshour/health/woodrow-wilson-stroke
Timestamps
(00:00:00) - Welcome to ThemeAntics
(00:00:48) - Introducing the Theme
(00:04:50) - Designated Survivor
(00:11:20) - Head of State (Chris Rock - 2003)
(00:21:30) - House of Cards
(00:31:40) - Code Geass: Lelouch of the Rebellion (Anime -2003
(00:42:00) - Antics Segment
Website: https://themeanticspodcast.podbean.com/
Email: ThemeAnticsPod@gmail.com
Blog: https://medium.com/@themeanticspodcast
Linktree: https://linktr.ee/ThemeAnticsPodcast
Devonte’ is back as a new dad! He shares his personal experiences with fatherhood and a time capsule message to his son for the future. Afterwards, Devonte’ and Bradston discuss a variety of stories that have parent-child relationships as a major theme.
The two then examine unique ways of telling these stories that allow the audience to think outside the box for how the parent-child dynamic can be defined and expressed.
Timestamps
(00:00:00) - Welcome to ThemeAntics
(00:00:48) - Introducing the Theme
(00:03:40) - Check-in with Devonte’ (Life as a New Parent)
(00:15:00) - The Pursuit of Happyness (Will Smith)
(00:25:35) - The Passage (Justin Cronin)
(00:40:30) - Finding Nemo (Disney)
(00:51:20) - The Final Empire (Brandon Sanderson)
(01:03:32) - Antics Segment
Website: https://themeanticspodcast.podbean.com/
Email: ThemeAnticsPod@gmail.com
Blog: https://medium.com/@themeanticspodcast
Linktree: https://linktr.ee/ThemeAnticsPodcast
In this episode, Bradston dives into the world of Isaac Asimov, one of the most prolific and influential Science Fiction writers of the 20th century. He discusses the life of Asimov and what solidified him as one of the "Big Three" Sci-fi writers of his era, along with Robert A. Heinlein and Arthur Clarke.
Join this journey of robotics, positronics and psyhcohistory as this episode dives into who Isaac Asimov was and takes a look at the genre defining narratives he created.
Timestamps
(00:00:00) - Welcome to ThemeAntics
(00:00:48) - Introducing to Episode
(00:02:40) - Who is Isaac Asimov?
(00:04:45) - Personal History of Asimov
(00:11:00) - The Writings of Asimov
(00:15:00) - Bradston’s Thoughts on Asimov
(00:15:25) - The Three Robotic Laws
(00:16:10) - Bradston’s Thoughts on Asimov (Continued)
(00:18:15) - I,Robot(1950)
(00:27:00) - The Gods Themselves (1972)
(00:34:00 - The Foundation Series (1951-1993)
(00:37:50) - The Caves of Steel & The Naked Sun (1953 & 1956)
(00:45:42) - Antics with Asimov
Website: https://themeanticspodcast.podbean.com/
Email: ThemeAnticsPod@gmail.com
Blog: https://medium.com/@themeanticspodcast
Linktree: https://linktr.ee/ThemeAnticsPodcast
Check out this special update from Devonte' and here some news on what's to come for ThemeAntics!
Website: https://themeanticspodcast.podbean.com/
Email: ThemeAnticsPod@gmail.com
Blog: https://medium.com/@themeanticspodcast
Linktree: https://linktr.ee/ThemeAnticsPodcast
What happens when you mix ancient alien civilizations, a worldwide mega-religion, and a body morphing android into one cohesive story? You get the Safehold Series and Off Armageddon Reef by David Weber.
In this episode, we explore the complex tale of human survival and the arrogance of man in Off Armageddon Reef. We do a full story synopsis of this epic book 1 in the Safehold series and then discuss the story implications and unanswered questions. Join us as we take a deep dive into storytelling and story analysis.
Timestamps
(00:00:00) - Welcome to ThemeAntics
(00:00:48) - Introducing the Story Deep Dive
(00:05:20) - The Story Synopsis of Off Armageddon Reef
(00:49:48) - Exploring the Story and Lingering Questions of Off Armageddon Reef
Website: https://themeanticspodcast.podbean.com/
Email: ThemeAnticsPod@gmail.com
Blog: https://medium.com/@themeanticspodcast
Linktree: https://linktr.ee/ThemeAnticsPodcast
If it's the wild cannon and the straight man, or if it's best friend fighting to protect what they love, we all love ourselves a good buddy movie. In this episode Devonte' and Bradston rediscover some of their favorite buddy movies and uncover some unique ideas buddy movies have yet to explore.
Timestamps
(00:00:00) - Welcome to ThemeAntics
(00:00:48) - Introducing the Theme
(00:02:51) - Midnight Run (Robert DeNiro and Charles Grodin)
(00:11:50) - Identity Thief (Jason Bateman and Melisa McCarthy)
(00:19:20) - Bad Boys (Martin Lawrence and Will Smith)
(00:26:05) - Rush Hour (Chris Tucker and Jackie Chan)
(00:33:45) - Antics Segment
Website: https://themeanticspodcast.podbean.com/
Email: ThemeAnticsPod@gmail.com
Blog: https://medium.com/@themeanticspodcast
LinkTree: https://linktr.ee/ThemeAnticsPodcast